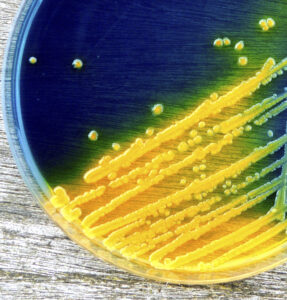

Natural Pool Knowledge Base
Basement swimming pools: Maximise the space beneath your feet
Basement conversions have been popular for sometime in London and other cities where space is at a premium. Having branched into the roof space
Jacks Natural Pool Facts – Bacteria Rule!
I asked our resident scientist, Dr Jack Lee, over a cup of tea this week, why he found bacteria so fascinating………and the first in a series
Top 10 tips for Building a DIY Natural Pool – by Professional Pool Builders
Chemical free swimming has been big news this week. With the Kingscross Pond Club opening over the bank holiday and the M&G garden at
Five Reasons your Garden will Thank You for Choosing a Natural Swimming Pool
Natural swimming pools are popular amongst nature lovers because of their softened impact on the garden environment compared to conventional pools, as well as